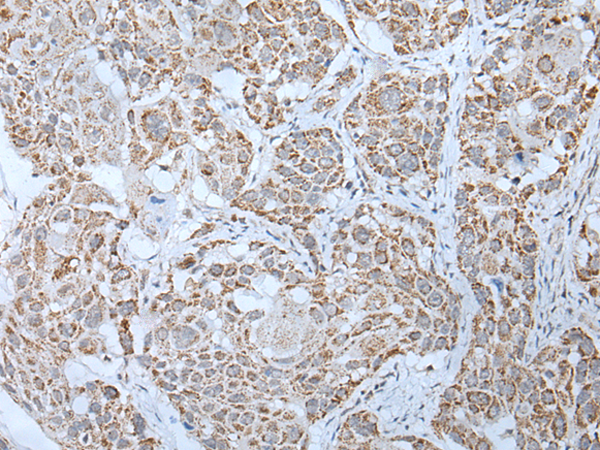

|
Background: |
This gene encodes the receptor for both luteinizing hormone and choriogonadotropin. This receptor belongs to the G-protein coupled receptor 1 family, and its activity is mediated by G proteins which activate adenylate cyclase. Mutations in this gene result in disorders of male secondary sexual character development, including familial male precocious puberty, also known as testotoxicosis, hypogonadotropic hypogonadism, Leydig cell adenoma with precocious puberty, and male pseudohermaphtoditism with Leydig cell hypoplasia. |
|
Applications: |
ELISA, IHC |
|
Name of antibody: |
LHCGR |
|
Immunogen: |
Synthetic peptide of human LHCGR |
|
Full name: |
luteinizing hormone/choriogonadotropin receptor |
|
Synonyms: |
HHG; LHR; LCGR; LGR2; ULG5; LHRHR; LSH-R; LH/CGR; LH/CG-R |
|
SwissProt: |
P22888 |
|
ELISA Recommended dilution: |
5000-10000 |
|
IHC positive control: |
Human esophagus cancer and human lung cancer |
|
IHC Recommend dilution: |
25-100 |

購物車
購物車 幫助
幫助
 021-54845833/15800441009
021-54845833/15800441009
